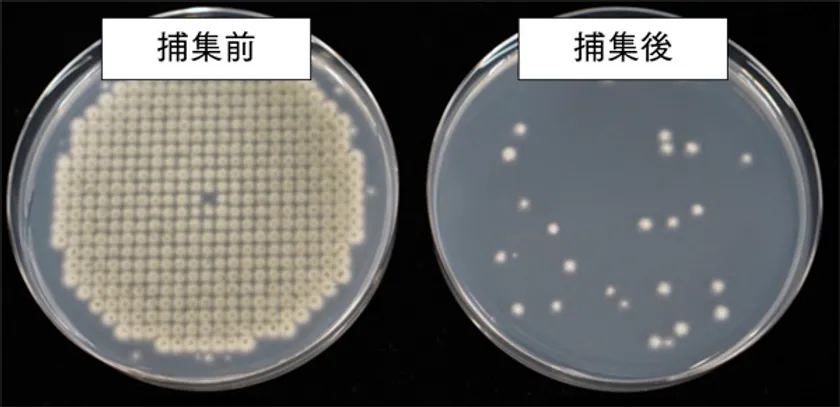

一台で花粉、浮遊カビなどお家まるごと空気清浄!(※1) 電気代もフィルタ代も節約できる 「電子式集塵フィルタ吸気ボックス FB40JB」2月より発売
住宅換気用フィルタ及び業務用空気清浄機を製造・販売する株式会社トルネックス(本社:東京都中央区/代表取締役:松井 周生)は、戸建て住宅の室内にフィルタでキレイな空気を循環させ、天井にスペースを取らずに収納できるビルトイン空気清浄機「電子式集塵フィルタ吸気ボックス FB40JB」を開発し、2023年2月より発売します。
新型コロナの感染拡大により、空気の質に対する意識が高まり、多くのご家庭では空気清浄機の導入が進んでいます。しかし、昨今の電気代高騰により、家計への負担が増えている中で、寝室やリビング、子供部屋など気になる部屋の空気をキレイにするには、何台の空気清浄機が必要になるでしょうか?また、新型コロナ感染防止対策のため、寒い日に窓開け換気を行うと暖房効率が悪くなり、無駄な電気代が増えます。さらに春先は、ドアや窓の開閉により花粉や黄砂がお家の中に進入すると、室内空気を汚すことになってしまいます。
今回発売する「電子式集塵フィルタ吸気ボックス FB40JB」は、戸建て住宅用ビルトイン空気清浄フィルタボックスです。一家に一台だけで空気清浄、送風ファンを組み合わせて設置することで空気を循環させることができるため、一般的には空気清浄機を置かない廊下や玄関にも清浄した空気が行き渡ります。一台分の電気代のみで家じゅうまるごと空気清浄します。
トルネックスが自社開発した「電子式集塵フィルタ吸気ボックス FB40JB」に搭載している電子式集塵フィルタは、全国の喫煙所を始め、病院の手術室、空港ターミナルビル等、より高いレベルの空気清浄度が求められる施設に導入されており、PM2.5よりさらに小さなタバコの粉塵(0.3μm以上)を95%除去(※2)、浮遊ウイルスや浮遊カビを除去します。電子式集塵フィルタは、一般的な微小粒子フィルタと異なり、目詰まりしにくいので、メンテナンス時まで吸引量はほぼ変わりません。また、ユーザーによる洗浄再生利用が可能なフィルタであるため、交換用フィルタのコストがかからず、しかもゴミが出ないため環境へ負荷を軽減します。
今回発売する「電子式集塵フィルタ吸気ボックス FB40JB」は、戸建て住宅を中心にオフィスや商業施設、公共施設、病院など人が集まるスペースでの利用も想定しています。価格は、オープン価格で2023年2月から販売を開始します。
※1 空気中の有害物質をすべて除去できるものではありません。電子式集塵フィルタでは、新型コロナによる検証はしておりません。
※2 光散乱式気中粒子計数器にて、風量120m3/h 粒子径0.3μm以上の粒子除去率をフィルタ単体で測定。循環風量により除去率は異なります。
◆電子式集塵フィルタ吸気ボックス FB40JBについて
【製品写真】

電子式集塵フィルタ吸気ボックス FB40JB
※状況により仕様が変更することがございます。
【設置イメージ】

設置イメージ
【仕様】
接続ダクト径:Φ150×1口
外形寸法 :W391×D391×H225mm
質量 :11kg
電源 :AC100V 50/60Hz
消費電力 :11W
定格風量 :350~400m3/h
【ビルトイン空気清浄機の特長】
・省エネ
低消費電力11W家庭用空気清浄機よりお得。
・1台で空気をキレイにしながら家じゅう空気循環
例えば、リビングから吸気した空気を清浄後、寝室や子供部屋に送ることで、空気清浄機を置かない場所にもキレイな空気を配ります。
・集塵効率
風量250m3/h:0.3-0.5μm 46%、0.5-1.0μm 50%、1.0-2μm 54%
風量300m3/h:0.3-0.5μm 46%、0.5-1.0μm 50%、1.0-2μm 52%
風量350m3/h:0.3-0.5μm 43%、0.5-1.0μm 47%、1.0-2μm 52%

集塵効率
・目詰まりしづらく、性能がほぼ変わらないフィルタ
高い集塵性能を持ちながらも、一般的な微小粒子フィルタと異なり、フィルタが目詰まりしづらく、フィルタ交換時まで吸引量はほぼ低下しません。
・メンテナンスコストゼロ
電子式集塵フィルタはご自宅で繰り返し洗浄再生可能。メンテナンス時期お知らせ機能標準搭載。
・設置しやすい
点検口の必要が無く、究極のスッキリデザイン。吸引量の多い送風ファンにも対応。施工性が良く空調経路に取り付け易い。
【電子式集塵フィルタは第三者機関での試験を実施】
浮遊ウイルス除去性能評価試験
浮遊カビの除去性能評価試験(千葉大学真菌医学研究センター 矢口 貴志准教授監修)
ダクト接続による浮遊カビワンパス除去性能評価試験
トルネックスの電子式集塵フィルタは、浮遊カビが1回通過した時の捕集効率が非常に高くなっています。
浮遊カビの除去性能評価試験
(フィルタ1回通過)
捕集効率 90%以上
浮遊カビの除去性能評価試験
試験方法:
電子式集塵フィルタの1次側でカビを散布。1次側と2次側のカビを採取。
◆ビルトイン空気清浄機Webサイト:
お家の空気の重要性をわかりやすく解説した特設ページを公開
https://www.gaiki-seijouki.jp/built-in/
*「今日から使えるご提案書」ダウンロード受付中!

























